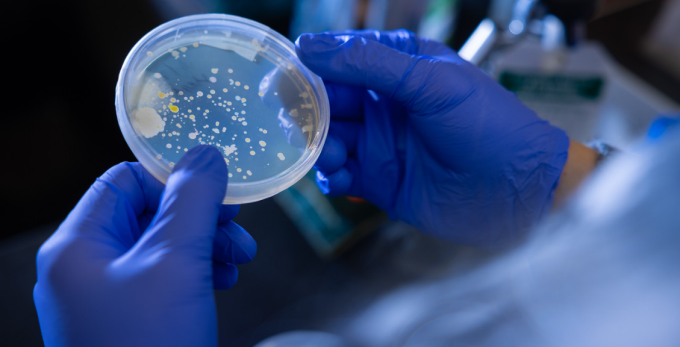
Gloved hands hold a petri dish containing bacterial colonies growing on agar, viewed close up in a biology laboratory.

Microbiology focuses on life forms too small to see but too important to ignore. From bacteria and viruses to protozoans and microscopic fungi, this research area explores how microorganisms survive, interact and influence ecosystems, health and evolution.
Great for students interested in health sciences, molecular biology, genetics, ecology, biotechnology or infectious disease.
Microbiology research asks questions such as:
Understanding microbial life helps explain everything from disease to nutrient cycling.
Microbiology research examines microorganisms in both natural and controlled environments. Studies may focus on microbial ecology, molecular regulation or evolutionary adaptation, often using bacteria, protozoans, yeasts and viruses as model systems.
By combining genetics, molecular biology, microscopy and ecological approaches, microbiology reveals how simple organisms carry out complex behaviors and interactions.
Microbiology commonly explores:
Together, these approaches uncover how microbial life drives biological systems at every scale.
Genetics, genomics, fungal biology, cellular signaling, cell and molecular biology, ecology and evolution
Students can gain hands-on experience studying microorganisms through lab research that builds skills in experimental design, data analysis and scientific communication. These projects provide strong preparation for careers in research, health care, biotechnology and graduate study.